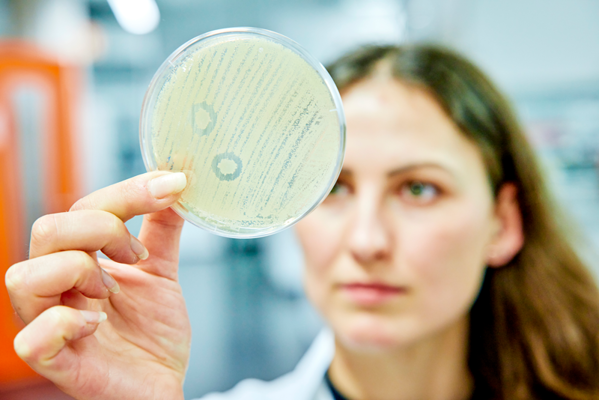

Exzellenzcluster "Controlling Microbes to Fight Infections" (CMFI)
Unsichtbares sichtbar machen – Ein Tag als Mikrobiologin
23.04.2026|10:00 – 14:00 Uhr |freie Plätze: 0/14 |barrierefrei

Was macht eigentlich eine Mikrobiologin? Ziemlich viele faszinierende Dinge, wie wir finden!
Bei uns erhältst du einen Einblick in die spannende Welt der Mikrobiologie.
Gemeinsam mit Forscherinnen unseres Exzellenzclusters werdet ihr Unsichtbares sichtbar machen und die Technik in Zell- und Mikrobiologischen Laboren kennenlernen: Wir extrahieren DNA, schauen uns an, welche Mikroben auf Alltagsgegenständen wie z.B. Smartphones siedeln und lassen unterschiedliche Bakterien wachsen. Das Treiben der Mikroben beobachten wir unter dem Mikroskop.
In Zell- und Mikrobiologischen Laboren kommt heutzutage einiges an Labortechnik zusammen. Die Forscherinnen nutzen z.B. sehr spezielle und komplexe Mikroskope, um Zellbewegungen zu beobachten. Auch bei der Auswertung der Experimente spielt die Bioinformatik eine immer größere Rolle. Daher zeigen wir euch anschließend unsere Forschungslabore und mit welcher Technik dort gearbeitet wird. Unser Angebot soll Einblick in die Laborarbeit und den Beruf „Mikrobiologin“ ermöglichen. Es sind keine Vorkenntnisse erforderlich.
Das Angebot richtet sich an Schülerinnen der 6./7. Klassenstufe.
Dieses Angebot ist barrierefrei
Wenn du begleitende Unterstützung benötigst, melde dich bitte im Vorfeld bei uns. Bei weiteren Fragen ruf uns gerne an oder schreib eine E-Mail. Wir können dann deinen Besuch vor Ort gemeinsam planen.
Wichtiger Hinweis zur Anmeldung
Zur Teilnahme an diesem Angebot musst du mindestens 11 Jahre alt sein.